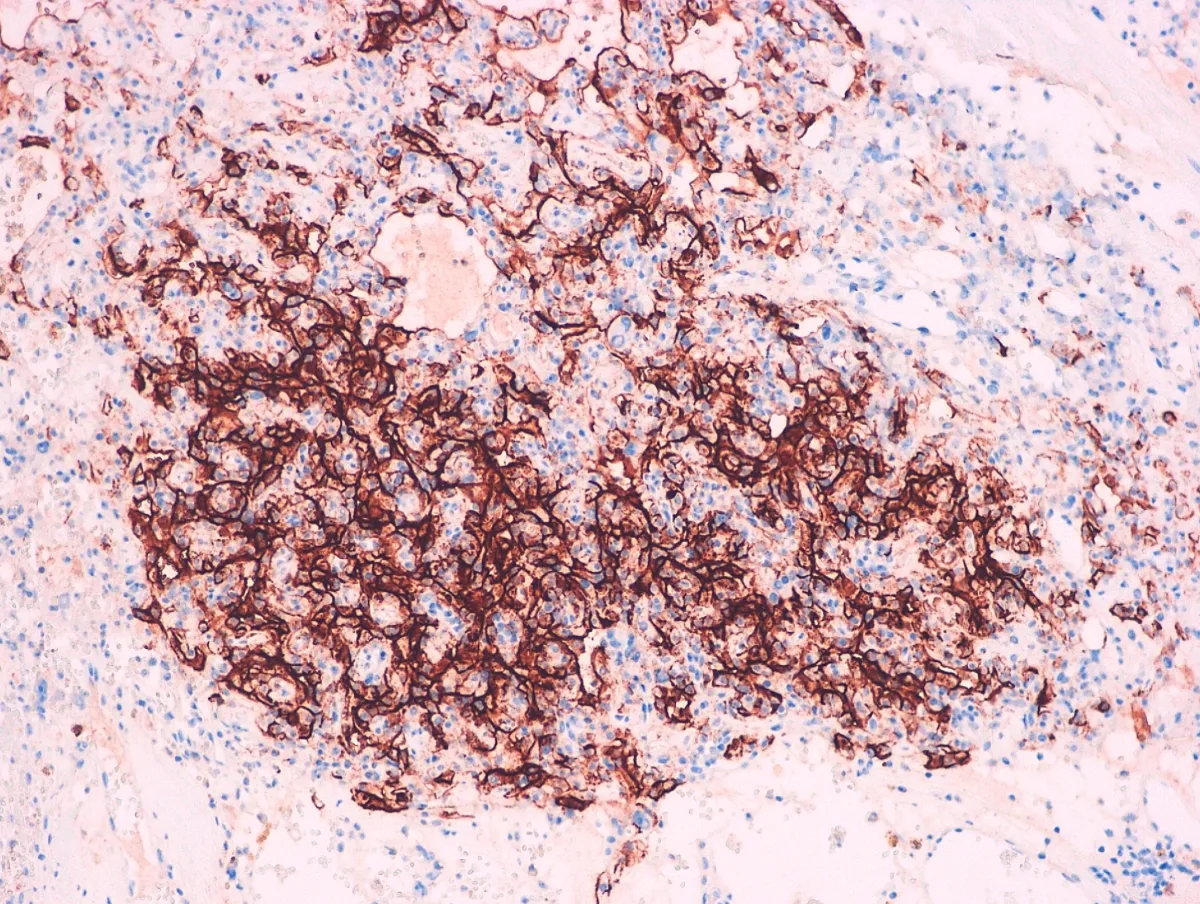

Enhorabuena a Celia Jiménez Revilla, residente de 3º año del Hospital Universitario Fundación Alcorcón, por ser el autor de nuestro CASO DE CORRELACIÓN CITO-HISTO del MES DE MARZO 2025.
DESCRIPCIÓN DEL CASO:
Varón de 37 años originario de Marruecos, antiguo trabajador de la construcción. Diagnosticado de Síndrome de Von Hippel Lindau tras la extirpación de varios hemangioblastomas en hemisferio cerebeloso derecho y tras posterior confirmación mediante estudio genético.
En seguimiento por su enfermedad, se realizó un TAC toraco-abdomino-pélvico que mostró dos nódulos en la cortical renal izquierda, ascitis generalizada y engrosamiento nodular e irregular del peritoneo. Se consideró como primera opción una carcinomatosis peritoneal de las lesiones renales y como segunda opción una tuberculosis peritoneal.
El estudio citológico del líquido ascítico demostró una población mesotelial. Se realizó una laparoscopia exploradora, observando múltiples implantes en el peritoneo parietal, omento y ambos ángulos cardiofrénicos. Se extirpó el implante de mayor tamaño (2 cm), localizado en el omento mayor.
Imágenes:

1-papanicolau-cito

2-papanicolau63x-cito

3-HE1

4-HE2

5-BerEP4

6-MOC31

7-Calretinina

8-CK5-6

9-D2-40

10-EMA
11-HBME1

12-WT1
¿Cuál es tu diagnóstico?
El diagnóstico y los aspectos esenciales de esta entidad se encuentran a continuación…
Diagnóstico: MESOTELIOMA EPITELIOIDE DIFUSO PERITONEAL
Aspectos esenciales:
- Neoplasia maligna de membranas serosas relacionada con la exposición a fibras de asbesto.
- El diagnóstico de mesotelioma no puede realizarse adecuadamente en una citología puesto que no permite valorar si existe invasión.
- La localización más frecuente es la pleura visceral, el peritoneo es la segunda ubicación en frecuencia y representa un 15-20% del total (PMID: 31283845).
- Suele presentarse con diseminación abdominal extensa y es indistinguible de una carcinomatosis peritoneal. La diseminación extraabdominal se da en casos de muy larga evolución.
- La morfología más frecuente es la epitelioide (75%), seguida de la sarcomatoide que confiere peor pronóstico. Las células se disponen formando túbulos, papilas o nidos sólidos (PMID: 15981812).
- Estos tumorales expresan Calretinina, Antimesotelio (HMBE1), Mesotelina, EMA, Trombomodulina, WT1, CK5/6, CK7, D2-40, Vimentina, Podoplanina y, en casos aislados, PAX-8 (PMID: 24183360).
- La principal alteración molecular asociada es la deleción en homocigosis de BAP1 o de CDKN2A, que, aunque no es exclusiva de estos tumores es característica y confiere un pronóstico pobre (PMID: 26493618).
- La mediana de supervivencia es de 50 meses y sin tratamiento de menos de 1 año. El tratamiento de elección es la cirugía citorreductora acompañada de HIPEC o de quimioterapia adyuvante (PMID: 36765620). Se están estudiando otras dianas terapéuticas incluyendo anti-PDL1, con resultados prometedores (PMID: 38384604).
- No está descrita su asociación con el Síndrome de Von Hippel Lindau, pero se han reportado 5 casos de mesotelioma peritoneal primario epitelioide, con células claras, con mutaciones en el gen VHL (PMID: 36515470; PMID: 33761726; PMID: 30118736).

